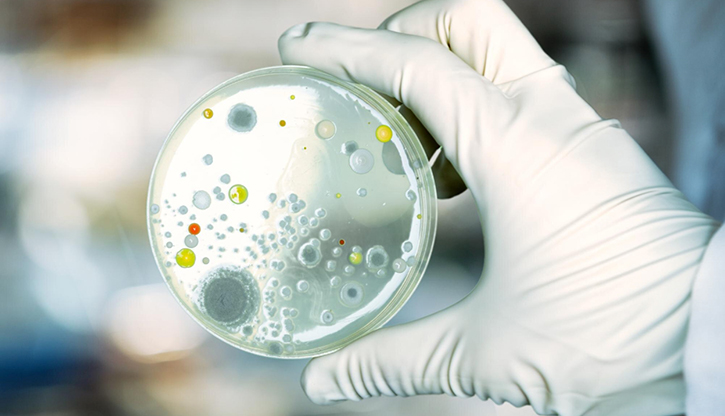

כשנכנסים לבית חולים, ובמיוחד לבית חולים לילדים, רובנו חושבים על טיפול, בדיקות, רופאים, אשפוז. אבל יש מערכת נוספת, בלתי נראית לרוב המבקרים, שפועלת בלי הפסקה כדי לשמור על מי שכבר הגיעו לכאן- מערכת הגנה שמונעת את מה שעלול לקרות, עוד לפני שזה מתחיל.
הכירו את החיידקים ולא כולם מסוכנים באותה מידה
בתוך בתי החולים, יש חיידקים שמצליחים "לשרוד" גם מול אנטיביוטיקות חזקות. לא כולם מסוכנים באותה מידה אבל כולם מחייבים התייחסות רצינית. להלן מספר דוגמאות:
MRSA
חיידק עמיד ממשפחת הסטפילוקוקוס – נמצא בעיקר בפצעים ובעור. לעיתים נשאות שקטה, אך מחייבת בידוד מניעתי.
ESBL
חיידקי מעיים (כמו אי-קולי) שמפרקים אנטיביוטיקות מסוימות. עלולים לגרום לזיהומים בדרכי השתן, הדם או מערכת העיכול.
CRE
חיידקים עמידים מאוד – גם לאנטיביוטיקות חזקות מסוג קרבפנמים. לרוב נמצאים בחולים עם אשפוזים ממושכים או טיפול חודרני.
Acinetobacter עמיד
חיידק סביבתי שמופיע לעיתים במשטחים וציוד. עלול לעבור בין חולים בבתי חולים צפופים, במיוחד כשמדובר בילדים מונשמים או פגיעים.
לא כל חיידק עמיד – אותו אתגר
"ההחלטות על בידוד, טיפול והתנהלות תלויות בזהות החיידק, במיקום שבו הוא נמצא בגוף ובמצב הקליני של הילד", מסבירה ד"ר מור. יש חיידקים שנמצאים בגוף בלי לגרום למחלה, אך עדיין מחייבים נוהל הפרדה כדי למנוע סכנה לילדים אחרים. ביחידה למניעת זיהומים של שניידר, נעשה ניתוח בזמן אמת של תוצאות התרביות, עדכון מיידי של הצוותים, ולעיתים התאמת נהלים תוך כדי תנועה".
"למה הילד שלי בבידוד?"
זוהי שאלה נפוצה שמעלים הורים, בעיקר כשאין סימנים למחלה. לעיתים, הם מתבקשים להיכנס לחדר נפרד, כשהצוות נכנס עם חלוק וכפפות, אף שבמבט ראשון הילד נראה בריא לחלוטין.
"חלק גדול מהבידודים שאנחנו עושים בבית החולים לא נובע ממחלה מדבקת, אלא מנשאות של חיידק עמיד," מסבירה ד"ר מור. הילד עצמו יכול להיות בריא לגמרי, אבל עלול להעביר את החיידק הלאה לילד אחר שמערכת החיסון שלו חלשה. הבידוד הוא אמצעי הגנה, לא עונש."
המשמעות בפועל- בידוד בחדר נפרד, ציוד מגן לצוות, הקפדה קפדנית על שטיפת ידיים ומגבלות ביקור מסוימות. כל אלו נועדו לצמצם למינימום את האפשרות של העברת חיידקים עמידים בין מטופלים.
המטרה שלנו היא לא לבודד אלא להגן
"אנחנו יודעים שלבידוד יש מחיר רגשי, לוגיסטי, לעיתים גם טיפולי, מסכמת ד"ר מור, אבל זו הדרך הכי טובה שלנו לשמור על הילדים, במיוחד אלו הפגיעים ביותר. אנחנו עושים את זה לא כי הם מסוכנים אלא כי הם כל כך חשובים."
גם טכנולוגיה וגם שיקול דעת אנושי
שגרת מניעת הזיהומים בבית החולים מתבססת על מערכות ניטור חכמות, שמצליבות נתוני מעבדה, התרעות קליניות ומעקב אחרי חיידקים עמידים. הצוות מקבל עדכונים מיידיים, מחליט על צעדים כמו בידוד, טיפול ממוקד או הסברה לצוותים, לעיתים עוד לפני הופעת תסמינים.
"אבל לצד הטכנולוגיה, מדגישה הד"ר, יש גם שיקול דעת: אנחנו בוחנים כל מקרה לגופו, מתוך ניסיון קליני, אחריות מקצועית והבנה עמוקה של הסיכון והאיזון."
המסר להורים: לשאול, להבין ולא לפחד
חשוב להסביר להורים שלא כל בידוד אומר שמדובר במחלה קשה. הבידוד לא נועד לבודד מהעולם אלא להגן שאלו את הצוות למה הילד מבודד, ואיך הכי נכון לפעול הקפידו על שטיפת ידיים וביקורים אחראיים
שניידר בתקשורת
חיידקים עמידים בבתי חולים הן אחת הצרות הכי גדולות שיש, במיוחד באוכלוסיית ילדים. רופאה בכריה ממרכז שניידר לרפואת ילדים מסבירה איך שומרים עליהם מוגנים.
"וואלה", 28.7.25

.jpg?BannerID=78)
.jpg?BannerID=79)

.jpg?BannerID=82)
.jpg?BannerID=83)
.jpg?BannerID=85)
.jpg?BannerID=84)

